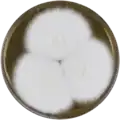
Aspergillus laciniosus growing on MEAOX plate

Aspergillus laciniosus
| Aspergillus laciniosus | |
|---|---|
| Scientific classification | |
| Kingdom: | Fungi |
| Division: | Ascomycota |
| Class: | Eurotiomycetes |
| Order: | Eurotiales |
| Family: | Aspergillaceae |
| Genus: | Aspergillus |
| Species: | A. laciniosus
|
| Binomial name | |
| Aspergillus laciniosus S.B. Hong, Frisvad & Samson (2006)[1]
| |
| Synonyms | |
|
Neosartorya laciniosa | |
Aspergillus laciniosus (also named Neosartorya laciniosa) is a species of fungus in the genus Aspergillus. It is from the Fumigati section.[2] The species was first described in 2006.[1] It has been reported to produce aszonalenins, tryptoquivaline, and tryptoquivalone.[2]
Growth and morphology
A. laciniosus has been cultivated on both Czapek yeast extract agar (CYA) plates and Malt Extract Agar Oxoid® (MEAOX) plates. The growth morphology of the colonies can be seen in the pictures below.
-
 Aspergillus laciniosus growing on CYA plate
Aspergillus laciniosus growing on CYA plate -
Aspergillus laciniosus growing on MEAOX plate
Aspergillus laciniosus growing on MEAOX plate
References
- ^ a b Hong, S.-B.; Cho, H.-S.; Shin, H.-D.; Frisvad, J.C.; Samson, R.A. 2006. Novel Neosartorya species isolated from soil in Korea. International Journal of Systematic and Evolutionary Microbiology. 56:477-486
- ^ a b Samson, R.A.; Hong, S.; Peterson, S.W.; Frisvad, J.C.; Varga, J. (2007). "Polyphasic taxonomy of Aspergillus section Fumigati and its teleomorph Neosartorya". Studies in Mycology. 59: 147–203. doi:10.3114/sim.2007.59.14. PMC 2275200. PMID 18490953.